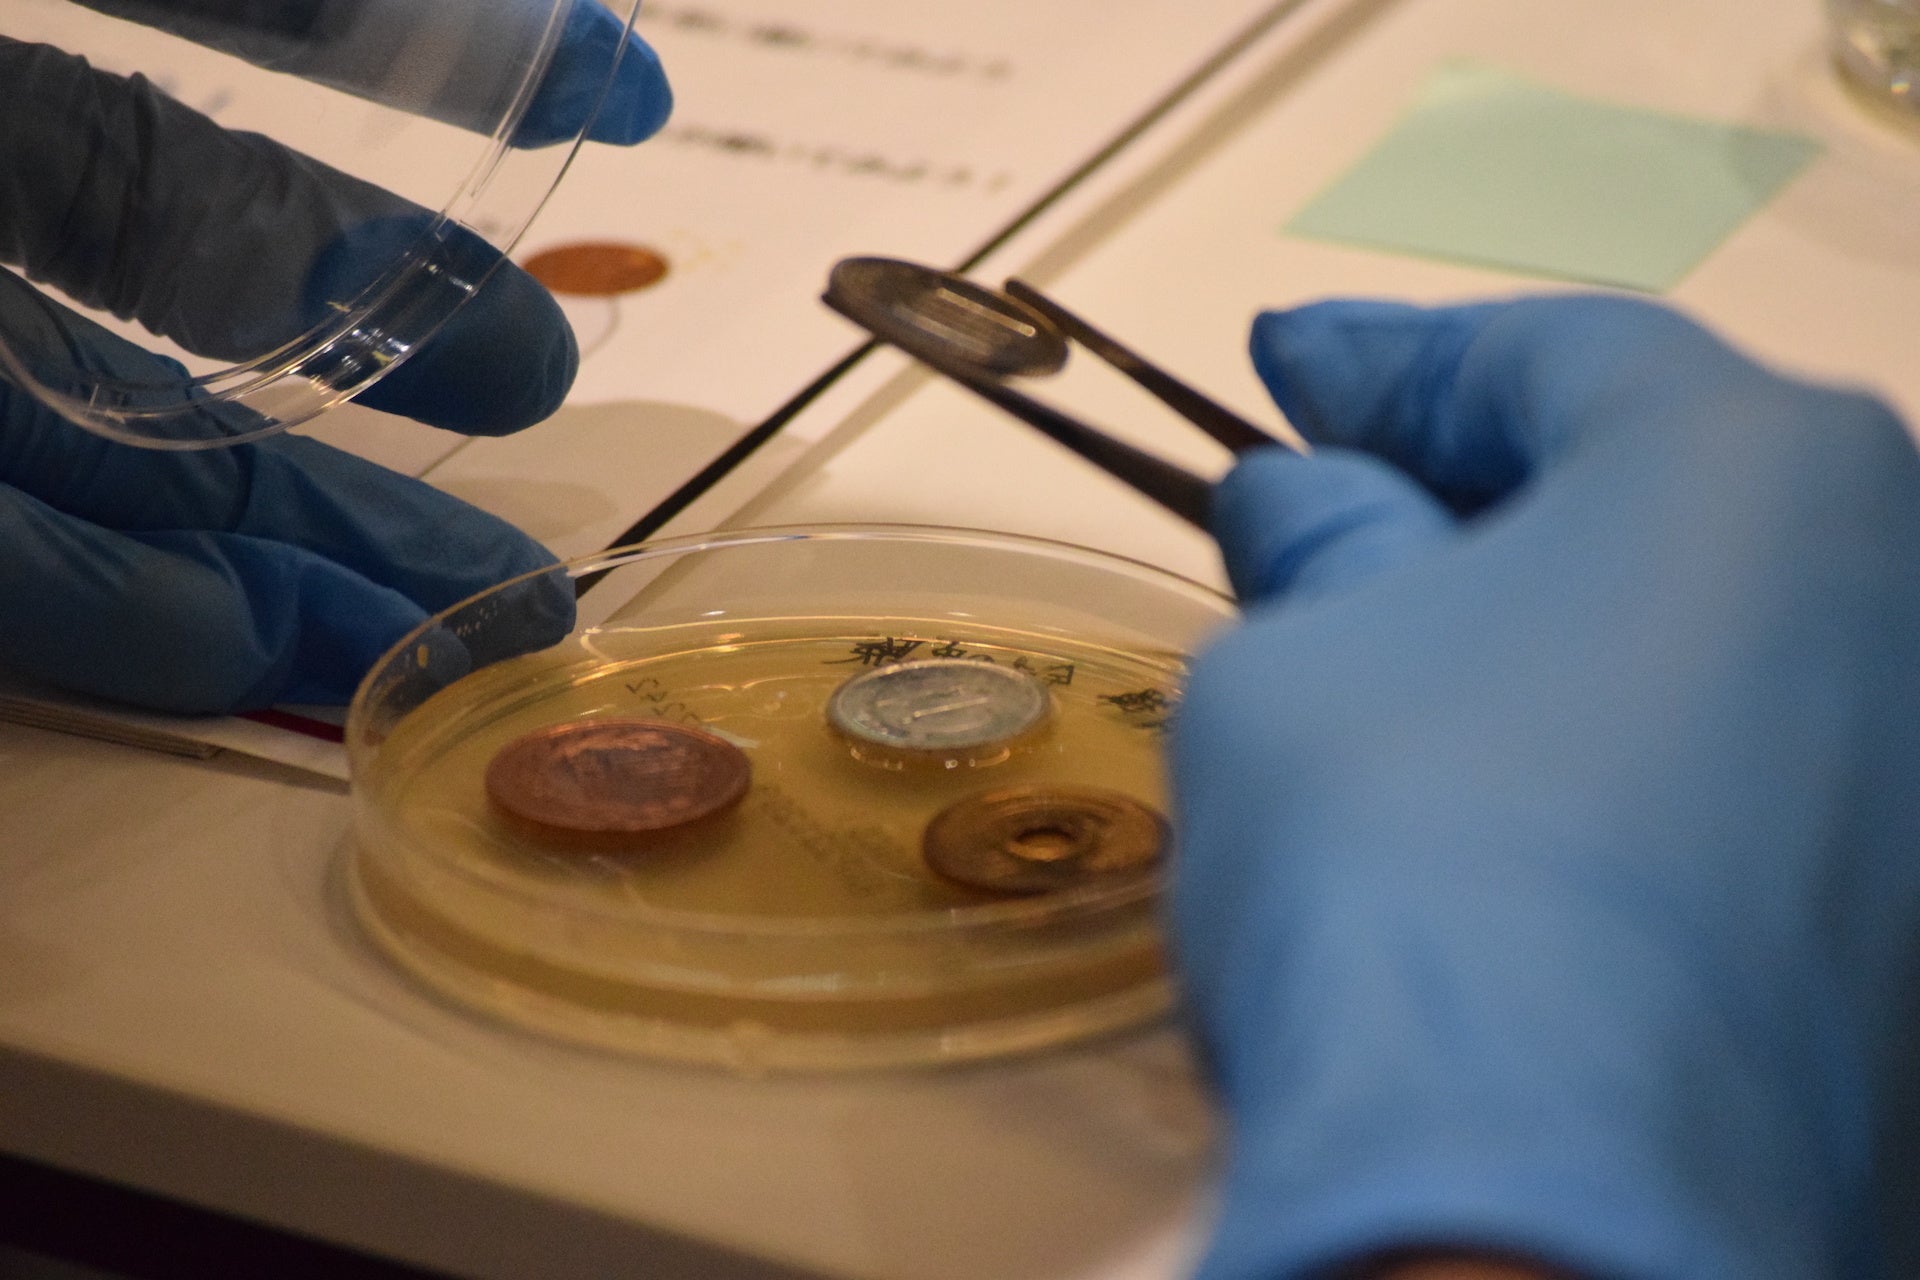
参加者は、銅の「超抗菌性能」を体験するため、唾液の上に銅の含有率が異なる硬貨を設置した

国際銅協会・日本銅センター、実験教室を初開催
中高生、新型コロナ対策など銅の活用法を学ぶ
国際銅協会(本部:米国ワシントンD.C.、会長:Stephen Higgins)と一般社団法人日本銅センター(東京都台東区、会長:納武士)は9月3日(土)、JX金属株式会社(東京都港区)本社内の「SQUARE LAB」で、実験教室「身近な「銅」の意外なチカラ!超抗菌性能を体験しよう!!」を初めて開催しました。参加した首都圏在住の中高生13人は、新型コロナウイルス感染症対策にも役立つ、銅の社会での役割について関心を深めました。今回のプログラムの開発・運営は株式会社リバネス(東京都新宿区)が手掛けました。
 実験教室で、銅の性質について学ぶ参加者の様子
実験教室で、銅の性質について学ぶ参加者の様子
イベントでは、まず銅の基本的な性質である「導電性(電気の伝わりやすさ)」と「熱伝導性(熱の伝わりやすさ)」を体験する実験が行われました。参加者は、銅、木、プラスチック、アルミニウム、真鍮(黄銅)などさまざまな材料を比較し、銅は電気・熱ともに最も通しやすいことを学びました。
次に、銅の「超抗菌性能」に関する講義と実験が行われました。銅・銅合金には、細菌などの増殖を抑える「超抗菌性能」やウイルスを不活化させる(感染性を失わせる)「抗ウイルス性能」があります。新型コロナウイルスを10分で不活化させる効果があることも、奈良県立医科大学などの試験(2021年)で分かっています。
今回は銅の「超抗菌性能」を体験するため、参加者の口腔内細菌を使って実験を行いました。参加者は採取した自身の唾液をシャーレに入れ、その上に1円玉(銅の含有率0%)、5円玉(同60~70%)、10円玉硬貨(同95%)、100円玉硬貨(同75%)をそれぞれ設置しました。このままシャーレを2~3日放置すると、1円玉の下以外は菌が繁殖しないことを確認することができます。
参加者は、銅の「超抗菌性能」を体験するため、唾液の上に銅の含有率が異なる硬貨を設置した
参加者は、銅の「超抗菌性能」を体験するため、唾液の上に銅の含有率が異なる硬貨を設置した
プログラムの最後には、銅の採掘から銅素材の紹介、リサイクルまで学べるJX金属株式会社の施設、「SQUARE LAB」の展示スペースの見学やJX金属製錬株式会社佐賀関製錬所(大分県大分市)の工場のVR見学を体験する時間もあり、参加者は興味のある分野についてさらに学びを深めました。
一般社団法人日本銅センターの和田正彦事務局長は、「中高生に向けて、実践的に銅の活用方法を学んでもらう機会を提供することができました。銅・銅合金には、新型コロナウイルスを10分で不活化する効果があります。今後、さまざまな場所でさらに銅の活用が進み、感染症対策など社会課題の解決に役立てもらいたいです」と述べました。
JX金属株式会社のESG推進部の野田麻由副部長は、「参加者が実験を行う姿勢や、ワークショップで積極的に発言する姿を見て、未来を担う若い世代との交流の機会の重要さをあらためて認識しました。今後もさまざまな方に非鉄金属の重要性やその魅力・可能性を知っていただくための活動を積極的に行っていきたいです」と述べました。
参加者からは、アンケートで「銅の超抗菌性能を活用して、社会に貢献できる製品を考えるのが楽しかった」「机上で得た知識を実際に体験することで、より深く内容を理解できた」などのコメントが出ました。
国際銅協会と一般社団法人日本銅センターは9月下旬以降に、群馬県でも同様の実験教室を開催する予定です。今後も感染症対策を含む、銅の社会でのさまざまな役割への関心を高める活動を続けていきます。
【開催概要】
⚫ 日時:2022年9月3日(土)14時00分~16時00分
⚫ 場所:JX金属株式会社「SQUARE LAB」
東京都港区虎ノ門二丁目10番4号 オークラ プレステージタワー
⚫ 対象:都内在住の中高生13人
⚫ 共催:国際銅協会、一般社団法人日本銅センター
⚫ 協力:JX金属株式会社
⚫ 運営:株式会社リバネス
【団体・会社概要】
国際銅協会
国際銅協会(International Copper Association, Ltd. 略称ICA)は、世界の銅産業のために銅市場を発展させ、国連が提唱する持続可能な開発計画(SDGs)への貢献を目指す非営利団体です。世界各国の銅鉱山、製錬会社など計 30 社が会員となっており、世界の電気銅生産量の6割を網羅しています。 日本では、JX金属株式会社、三菱マテリアル株式会社、住友金属鉱山株式会社が会員となっています。
※公式ウェブサイト:https://www.antimicrobialcopper.com/ja/
一般社団法人日本銅センター
一般社団法人日本銅センターは、銅および銅合金の新規用途・技術開発を効率的に行い、銅のすぐれた特性や機能を多くの人に周知することを目的に設立された機関です。日本鉱業協会、一般社団法人日本伸銅協会、一般社団法人日本電線工業会、国際銅協会の4団体を正会員に、多くの賛助会員の協力のもと、銅の需要開発・促進に向けてさまざまな調査・研究を行なっています。このほか各種出版物の発行など、幅広い広報活動を展開しています。
※公式ウェブサイト:http://www.jcda.or.jp/
このプレスリリースには、メディア関係者向けの情報があります
メディアユーザーログイン既に登録済みの方はこちら
メディアユーザー登録を行うと、企業担当者の連絡先や、イベント・記者会見の情報など様々な特記情報を閲覧できます。※内容はプレスリリースにより異なります。
すべての画像
